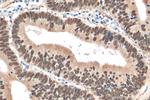
CDX2 Antibody in Immunohistochemistry (Paraffin) (IHC (P))

Search
Proteintech
CDX2 Polyclonal Antibody
{{$productOrderCtrl.translations['antibody.pdp.commerceCard.promotion.promotions']}}
{{$productOrderCtrl.translations['antibody.pdp.commerceCard.promotion.viewpromo']}}
{{$productOrderCtrl.translations['antibody.pdp.commerceCard.promotion.promocode']}}: {{promo.promoCode}} {{promo.promoTitle}} {{promo.promoDescription}}. {{$productOrderCtrl.translations['antibody.pdp.commerceCard.promotion.learnmore']}}
产品信息
30380-1-AP
种属反应
宿主/亚型
分类
类型
抗原
偶联物
形式
浓度
规格
纯化类型
保存液
内含物
保存条件
运输条件
产品详细信息
Immunogen sequence: MYVSYLLDKD VSMYPSSVRH SGGLNLAPQN FVSPPQYPDY GGYHVAAAAA AAANLDSAQS PGPSWPAAYG APLREDWNGY APGGAAAAAN AVAHGLNGGS
靶标信息
The product of this gene is an epsilon subunit of coatomer protein complex. Coatomer is a cytosolic protein complex that binds to dilysine motifs and reversibly associates with Golgi non-clathrin-coated vesicles. It is required for budding from Golgi membranes, and is essential for the retrograde Golgi-to-ER transport of dilysine-tagged proteins. Coatomer complex consists of at least the alpha, beta, beta', gamma, delta, epsilon and zeta subunits. Alternatively spliced transcript variants encoding different isoforms have been identified.
仅用于科研。不用于诊断过程。未经明确授权不得转售。
篇参考文献 (0)
生物信息学
蛋白别名: caudal type homeo box 2; caudal type homeobox transcription factor 2; Caudal-type homeobox protein 2; CDX-3; HGNC:1806; Homeobox protein CDX-2; homeobox protein miniCDX2
基因别名: CDX-2; CDX-3; CDX2; CDX2/AS; CDX3
UniProt ID: (Human) Q99626, (Mouse) P43241
Entrez Gene ID: (Pig) 100127132, (Human) 1045, (Mouse) 12591, (Rat) 66019